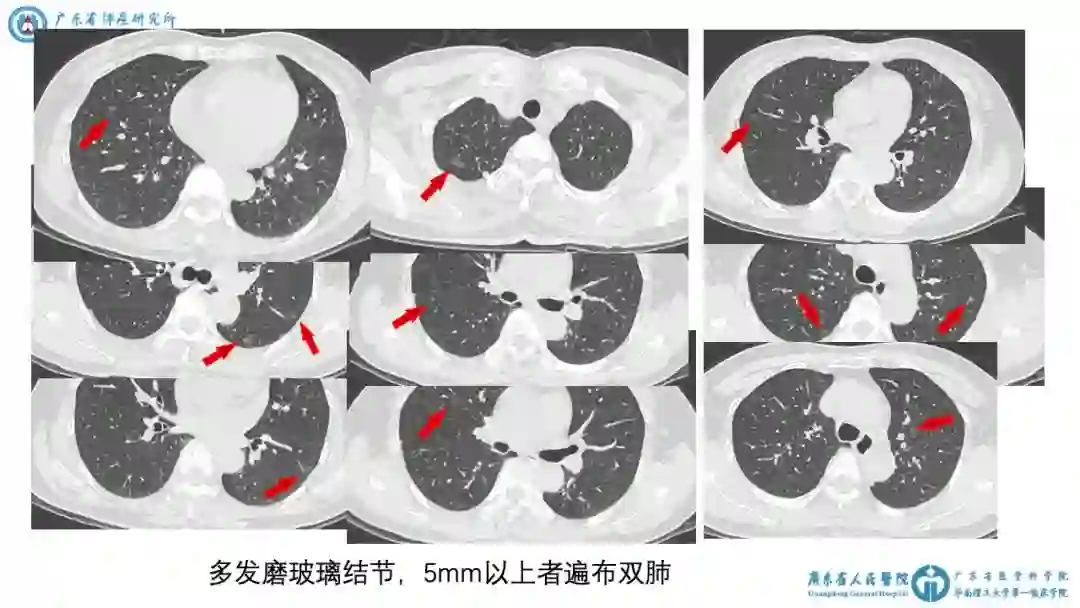
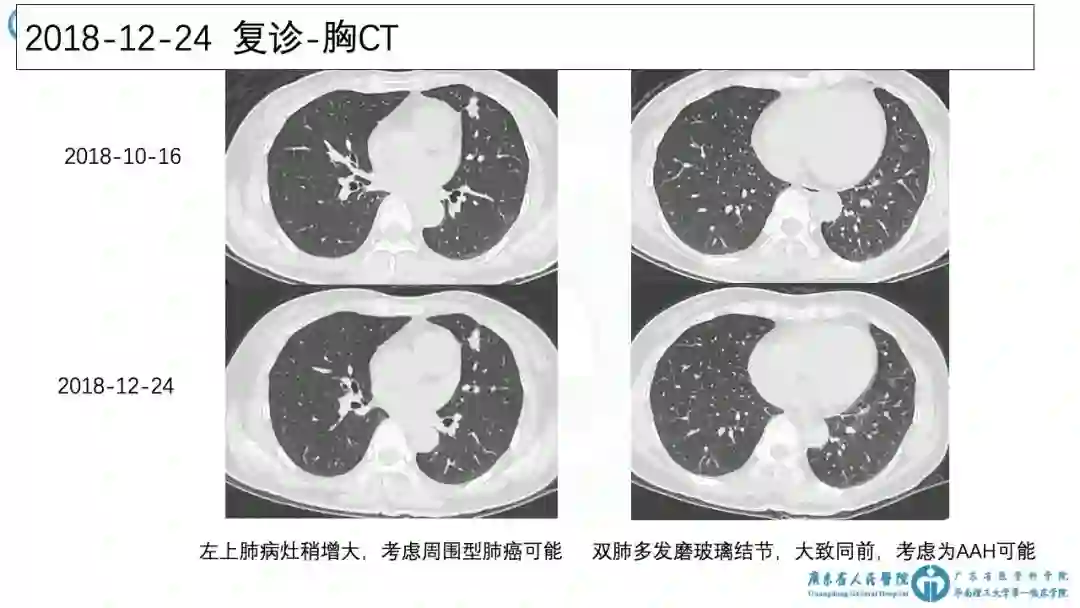

伴有可疑肾上腺转移的双侧多发肺结节,多科室意见大讨论 · 上 | 龙哥查房

「龙哥查房」重磅回归
「龙哥查房」系肿瘤资讯于2017年11月开展的专题,通过与广东省人民医院肺科大查房合作,将其中具有代表性的MDT病例讨论部分搬到网络进行连载,旨在让全国肿瘤医生都有机会跟随吴一龙院长学习规范的循证医学诊疗思维模式,最终造福肿瘤患者。
病例 55 · 上
- 病理篇 -
讨论时间
2019 年 3 月 6 日
汇报人员
广东省人民医院胸外科 邓澄
参与专家
吴一龙(教授、主任医师、博导)
张绪超(研究员、硕导)
杨衿记(主任医师、博导)
杨学宁(主任医师)
钟文昭(主任医师、博导)
周清(主任医师、博导)
涂海燕(副主任医师)
陈晓明(主任医师、硕导)
李伟雄(主任医师)
潘燚(副主任医师)等
患者病史:2018-09-30 初诊
1)患者:女,56岁,PS=0。
主诉:发现肺占位性病变2月余。
现病史:患者2018年8月当地体检发现左肺占位性病变,未见片,未治疗。未诉不适。
既往史:高血压病史6年,最高150~160/90mmHg,未规律服药,诉自测血压基本正常。
个人史:无吸烟史。
家族史:无明确肺癌家族史。
体格检查:阴性。
2)2018-10-16 胸CT平扫+增强:①左肺上叶斑片影,考虑慢性炎症。②多发磨玻璃结节,最大者左下肺8mm。③多发磨玻璃结节,5mm以上者遍布双肺。
3)病例特点:
中老年女性,偶然发现肺多发磨玻璃结节,无伴肺癌高危因素,伴有孤立实性病灶,考虑炎症。
初步诊断:肺多发结节,肺癌待排。
图表资料

讨论要点 :随访
1)此患者应随访还是干预?
科内意见
炎症-口服莫西沙星1周。
2)若进行随访,下次复诊时机为何时?
科内意见
3个月后复查CT。
患者病史:2019-01-04 入院
入院完善血常规、肝肾功能等检查未见显著异常 。肿瘤指标未见异常。肺通气功能及心脏B超未见显著异常。
入院后予拜新同30mg qd控制血压,血压波动于120~140/70~90mmHg。
图表资料

讨论要点2:多结节的寡转移?
1)患者目前诊断与分期
① 患者双肺多发病变是否为同时多原发癌?
② 患者肾上腺病灶是否为寡转移癌?
科内意见
① 双侧多原发肺癌伴左侧肾上腺转移,cT1b(m)N0M1b,IVa期。
② 高血压病。
2)目前的处理策略
① 活检明确诊断 vs. 直接手术切除?
② 手术切除的范围和方式。
科内处理
行胸腔镜下左上肺及左下肺楔形切除,备左上肺叶切除+SND。
患者病史:2019-01-10 手术情况
1)上一阶段小结:
① 实性结节生长速度明显较快,与其他结节影像表现不同 。
② 最大GGO 8mm,与18mm实性主病灶位于同侧。
③ 两病灶位置均在外周,局部切除容易实现
④ 患者肺部病变为多发GGO,且存在可手术的实性主病灶。
⑤ 未见淋巴结转移证据。
2)手术情况:
① 行胸腔镜左肺楔形切除术,上下叶病灶冰冻病理均为浸润性腺癌。
② 考虑左上肺病灶为接近2cm的实性结节,行左肺上叶切除+SND。
③ 术后4天出院。
3)术后病理:
①(左上肺)浸润性腺癌,腺泡生长方式。
② 肿瘤最大径至少1.5cm。
③ 免疫组化:PD-1(MRQ-22)(免疫细胞1%+),PD-L1(22C3)(肿瘤细胞5%+),PD-L1(阴性试剂对照)(-)。
④(左下肺肿物)浸润性腺癌,腺泡生长方式(55%),贴壁生长方式(45%)。
⑤ 肿瘤最大径至少0.8cm。
⑥ 送检各组淋巴结未见癌。(共0/16,“肺门淋巴结”0/4;“叶间淋巴结”0/6;“下肺韧带淋巴结”0/1;“第4组淋巴结”0/2;“第5组淋巴结”0/1;“隆突下淋巴结”0/1;“下肺静脉旁淋巴结”0/1;淋巴结较破碎,计数仅供参考)
⑦ 左上肺结节NGS示:EGFR 21外显子 L858R突变,丰度32.45%。
4)术后诊断:
① 左上肺浸润性腺癌并左肾上腺孤立转移,pT1bN0M1b, Ⅳa期,伴有EGFR 21 外显子L858R突变。
② 左下肺浸润性腺癌,pT1aN0M0, Ⅰa1期。
③ 高血压病。
讨论要点3:携带EGFR敏感突变的多原发与寡转移
目前的处理策略
① 予EGFR-TKI靶向治疗。
② 手术切除肾上腺转移灶。
③ 术后观察随访。
图表资料

病例讨论
1)第一阶段讨论
2)病理科解读手术病理·1
3)第二阶段讨论
讨论未完待续,请期待明天发布的55·下篇!
TIPS:
进入 肿瘤医生APP「龙哥查房」专题查看精华版讨论内容。除病例及讨论内容外,还有 高解析度图片 以及本次MDT结合的 前沿热点、文献解读 等内容!
如果您对这个病例有相关的想法观点、疑问困惑,在评论区留言吧,查房团队也想听听同道们的意见,并对问题统一进行回复。

长按扫描下载肿瘤医生APP
临床工作 学习必备
一站式肿瘤专业应用
觉得有帮助,别忘记点在看噢




